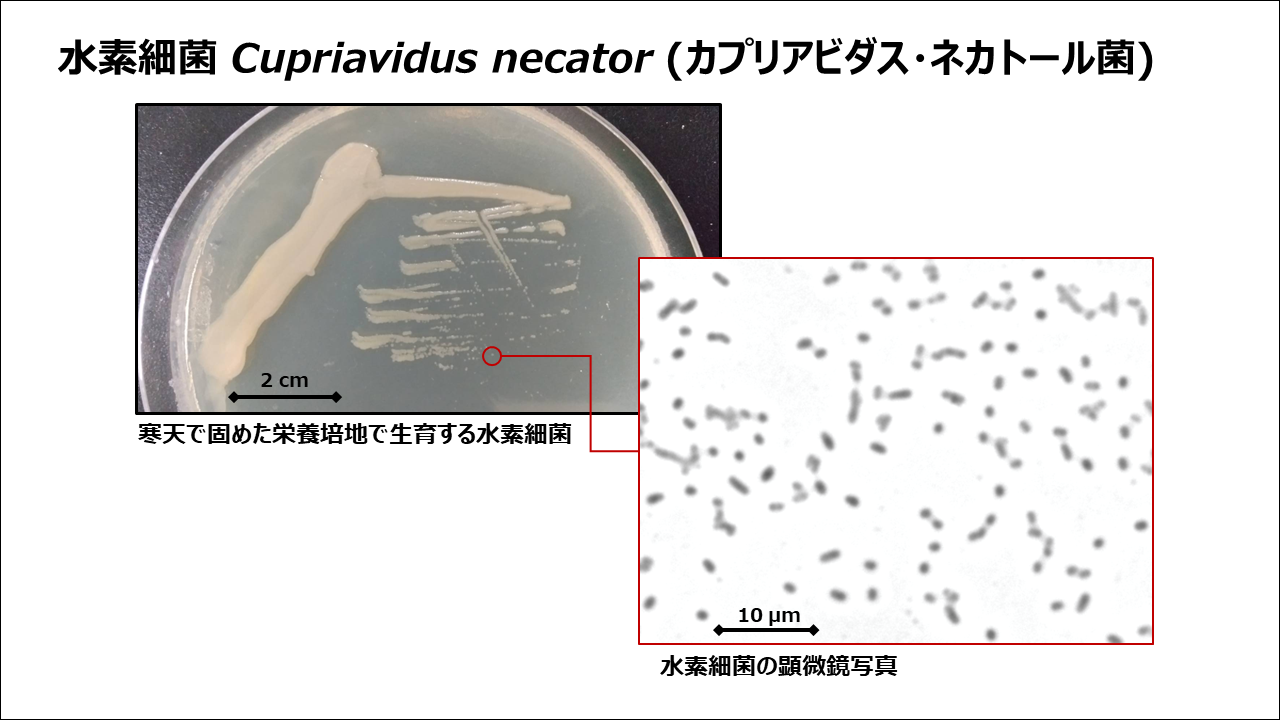

NEWS
微生物を使ったものづくりに関する研究がNHK NEWS WEBのビジネス特集に取り上げられました
バイオ生産工学研究室の近藤昭彦教授、蓮沼誠久教授、秀瀬涼太特命准教授らがおこなっている、微生物を使ったものづくりに関する研究が、7月25日に掲載されたNHK NEWS WEBのビジネス特集に取り上げられました。

NEWS
バイオ生産工学研究室の近藤昭彦教授、蓮沼誠久教授、秀瀬涼太特命准教授らがおこなっている、微生物を使ったものづくりに関する研究が、7月25日に掲載されたNHK NEWS WEBのビジネス特集に取り上げられました。